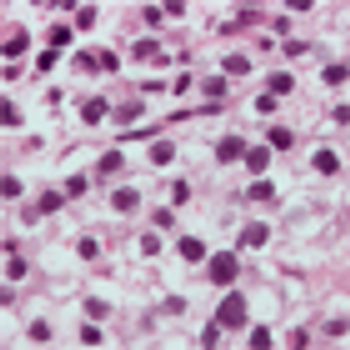

Zach Hartman
Articles by Zach Hartman


The anti-RANKL antibody denosumab is more effective for preventing bone metastasis in men with high-risk castration-resistant prostate cancer compared with low-risk disease, according to results of a new study.

Analysis of 18F FDG-PET standardized uptake values may be a useful technique for predicting survival in patients with inoperable stage III non–small-cell lung carcinoma, according to a new study.

Shift work is positively associated with higher levels of prostate-specific antigen (PSA) levels in men between the ages of 40 and 65, according to results of a new study.

Among non–small-cell lung carcinoma (NSCLC) patients, foreign-born Hispanics show less cancer-related mortality compared with US-born Hispanics and non-Hispanic whites, in part due to social and cultural environment, according to results of a new study.

Identification of a significant micropapillary component within lung adenocarcinomas predicts a higher risk of relapse following lung-sparing surgery, according to results of a new study.

The ALK-inhibitor crizotinib leads to longer progression-free survival than chemotherapy in patients with advanced ALK-positive non-small-cell lung cancer (NSCLC), according to results of a phase III clinical trial.

An assay system for gene expression analysis of paraffin-embedded patient samples is predictive of lung cancer histologic type, according to results published in the Journal of Molecular Diagnostics.

The addition of everolimus (Novartis) to combination trastuzumab/vinorelbine leads to a significant improvement in progression-free survival compared with placebo in advanced and metastatic HER2-positive breast cancer.
Surveillance of patients with stage I seminoma following orchiectomy can spare a majority of patients from adjuvant chemotherapy with a low risk of relapse, according to results presented at the 2013 ASCO meeting.

Palliative radiotherapy is an effective means of alleviating pain and improving overall quality of life in elderly patients with bone metastases, according to a new study.

A mouse model of bone metastasis can be used to follow real-time response to therapeutics in preclinical development, such as cabozantinib, according to results presented in the poster session of the 2013 AACR annual meeting.

The pan-AKT inhibitor ARQ092 was shown to be well-tolerated, avoiding dose-limiting toxicities that often haunt inhibitors of AKT signaling, according to results presented at the 2013 AACR meeting.

The THYME trial testing AZD8931 in advanced HER2-low breast cancer failed to reach the primary endpoint of progression-free survival, according to results of the phase II trial presented at the 2013 AACR meeting in Washington, DC.

The Wnt signaling pathway was demonstrated as a promising target in cancer stem cell therapy through a series of talks highlighting the promise and efficacy of a new generation of inhibitors that are making their way into the clinic.

Different dosing schedules of the pan-AKT inhibitor AZD5363 revealed key details about maximum tolerable dosages, and biochemical efficacy was suggested by analyzing biomarkers, according to the results of a phase I study presented at the 2013 annual meeting of the American Association of Cancer Research.

Trastuzumab (Herceptin) therapy may be useful for the treatment of luminal breast cancer stem cells, preventing them from growing into macrometastases, according to preclinical results presented at the 2013 American Association for Cancer Research Annual Meeting.

Targeting prostate cancer stem cells may be a method of treating prostate cancer while avoiding the development of resistance to androgen deprivation therapy, according to preclinical results presented at the annual meeting of the American Association for Cancer Research.

Radiolabeled small molecules targeting prostate-specific membrane antigen are well-tolerated tools for detection of metastatic prostate cancer, according to results of a phase I clinical trial.

Substitution of estrogen patches for luteinizing hormone-releasing hormone agonist therapy in men with castration-resistant prostate cancer has similar testosterone-depleting effects while improving metabolic side effects, according to results from the PATCH trial.





